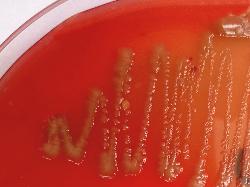

| Leclercia tamurae |
Taxonomy
Morphology
Cultural characteristics
Biochemical characters
Ecology
Pathogenicity
References
Phylum Pseudomonadota (Proteobacteria), Class Gammaproteobacteria, Order Enterobacterales, Family Enterobacteriaceae,
Genus Leclercia, Leclercia tamurae Maddock et al. 2023.
Genus Leclercia, Leclercia tamurae Maddock et al. 2023.
Gram-negative rods. Motile by peritrichous fagella
After 48h on TSA, colonies are circular, matte, brittle and cream-coloured with slightly
undulate margins with an average diameter of 3mm, yellow pigmentation. Grows at
10 and 41 °C, with optimal growth observed between 30 and 35 °C. Grows at pH6-9
and inf 1-8% NaCl. Facultatively anaerobic.
undulate margins with an average diameter of 3mm, yellow pigmentation. Grows at
10 and 41 °C, with optimal growth observed between 30 and 35 °C. Grows at pH6-9
and inf 1-8% NaCl. Facultatively anaerobic.
Isolated from healthy Quercus robur rhizosphere soil in Hatchlands, Guildford, UK.
Undetermined.
- Maddock D, Arnold D, Denman S, Brady C. Description of a novel species of Leclercia, Leclercia tamurae sp. nov. and proposal of
a novel genus Silvania gen. nov. containing two novel species Silvania hatchlandensis sp. nov. and Silvania confinis sp. nov.
isolated from the rhizosphere of oak. BMC Microbiol 2022; 22:289.
Positive results for catalase, indole production, esculin hydrolysis, ONPG, nitrate
reduction, N-acetyl-beta-glucosaminidase, acid production from: dulcitol, malonate,
sorbitol and rhamnose.
Negative results for arginine dihydrolase, citrate utilization (Simmons), H2S
production, lysine decarboxylase, ornithine decarboxylase, gelatin hydrolysis,oxidase,
urease, Voges-Proskauer test, acid production from: D-adonitol, D-arabitol,
2-ketogluconate, palatinose, D-raffinose, sucrose and tagatose.
Variable fermentation of 5-ketogluconate, D-lyxose, methyl-alpha-D-glucopyranoside
and D-trehalose.
Variable utilization of sucrose, D-salicin, 3-methyl glucose, D-serine, L-pyroglutamic
acid, citric acid, D-malic acid, tween 40, alpha-hydroxy-butyric acid, beta-hydroxy-D,
L-butyric acid and formic acid.
L. tamurae can be differentiated from L. adecarboxylata by utilization of citrate and
fermentation of adonitol and sorbitol.
reduction, N-acetyl-beta-glucosaminidase, acid production from: dulcitol, malonate,
sorbitol and rhamnose.
Negative results for arginine dihydrolase, citrate utilization (Simmons), H2S
production, lysine decarboxylase, ornithine decarboxylase, gelatin hydrolysis,oxidase,
urease, Voges-Proskauer test, acid production from: D-adonitol, D-arabitol,
2-ketogluconate, palatinose, D-raffinose, sucrose and tagatose.
Variable fermentation of 5-ketogluconate, D-lyxose, methyl-alpha-D-glucopyranoside
and D-trehalose.
Variable utilization of sucrose, D-salicin, 3-methyl glucose, D-serine, L-pyroglutamic
acid, citric acid, D-malic acid, tween 40, alpha-hydroxy-butyric acid, beta-hydroxy-D,
L-butyric acid and formic acid.
L. tamurae can be differentiated from L. adecarboxylata by utilization of citrate and
fermentation of adonitol and sorbitol.
(c) Costin Stoica

| Antibiogram |
| Encyclopedia |
| Culture media |
| Biochemical tests |
| Stainings |
| Images |
| Movies |
| Articles |
| Identification |
| Software |
| R E G N U M PROKARYOTAE |

| Back |
| Leclercia tamurae / L. adecarboxylata . yellow colonies on Sheep Blood Agar |
| Gram-negative cells |